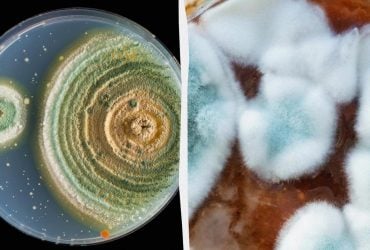
Проклятий гриб із гробниці, який убив 10 учених, може стати порятунком від раку

Минуло 100 років відтоді, як у Єгипті було виявлено останки фараона Тутанхамона, і тепер дослідник розкрив маловідомі подробиці цих розкопок.
Як пише видання Daily Mail, британський археолог Говард Картер і група єгипетських археологів виявили знамениту гробницю в Долині царів, але їм довелося обезголовити і знівечити мумію, щоб дістати її з труни.
Мумія фараона була укладена в оболонку зі стародавньої смоли, що залишилася від похоронного ритуалу, який відбувся в 1323 році до нашої ери, понад 3300 років тому.
Видання зазначило, що хоча Картер написав три книги про знахідки, він промовчав про подробиці розчленування. На думку експертів, це було зроблено, щоб не розкривати нешанобливе поводження з мумією.
"Розтин, що відбувся, був жахливим. Тутанхамон був "обезголовлений, його руки були відокремлені в плечах, ліктях і кистях, ноги - у стегнах, колінах і щиколотках, а тулуб - відтятий від таза по гребеню клубової кістки", - розкрила деталі Елеонора Добсон із Бірмінгемського університету.
"Його останки пізніше були склеєні, щоб імітувати ціле тіло - моторошна реконструкція, що приховує жорстокість процесу", - додала вона.
Ці одкровення про роботу вчених вдихнули нове життя в міф про те, що прокляття, яке приносить невдачу, хвороби і смерть, переслідує будь-кого, хто потривожить мумію єгипетського фараона.
Видання нагадало, що міф про прокляття фараона розійшовся по всьому світу після того, як ключові члени експедиції Картера померли за дивних обставин після того, як археологи виявили гробницю Тутанхамона.
Серед загиблих був лорд Карнарвон, спонсор Картера, який помер від зараження крові через укус комахи. Картер продовжував заперечувати існування прокляття аж до своєї смерті у віці 64 років від лімфоми Ходжкіна.
Через століття деякі дослідники, включно з Добсоном, стверджували, що Картер навмисно приховав жахливу страту Тутанхамона, щоб уникнути суспільного обурення.
Ці заяви набули ще більшої актуальності, коли дослідники в 1960-х і 1970-х роках виявили, що тіло Тутанхамона склеїли після розтину, щоб створити видимість незайманого.
Однак вчені десятиліттями сперечалися про те, чи був у Картера і археологів інший вибір у тому, як витягти тіло Тутанхамона, враховуючи обмежені ресурси 1920-х років.
У записах Картера зазначалося, що мумія повністю прилипла до дна труни, тому що жерці 3300 років тому облили фараона величезною кількістю густої нафти і смоли, яка затверділа, перетворившись на клей, подібний до каменю.
Протягом кількох днів вони тримали золотий саркофаг під палючим єгипетським сонцем, і навіть використовували лампи, щоб розтопити чорну смолоподібну субстанцію, що покривала Тутанхамона.
Однак, коли нічого не допомогло, Картер і анатоми Дуглас Деррі та Салех Бей Хамді вирішили силоміць витягнути фараона з труни, розжаривши звичайні ножі на вогні до червоного, щоб розплавити смолу.
Використовуючи ножі, зубила і молотки, вони буквально відкололи мумію від труни, спочатку знявши знамениту золоту маску Тутанхамона, а потім відрубавши йому голову. Потім команда розпиляла тулуб Тутанхамона навпіл і відламала йому руки і ноги в кожному суглобі.
Зрештою, тіло було розібрано на більш ніж 12 окремих частин, щоб витягти як мумію, так і безцінну золоту труну з коштовностями.
Через роки дослідження тіла Тутанхамона показали, що Картер і анатоми покривали кожен шматок гарячим парафіном, щоб захистити його від руйнування, а потім склеювали тіло смолою для експонування.
"Варто переосмислити спадщину розкопок Картера не тільки як віху в єгиптології, а й як момент етичного переосмислення", - прокоментувала Добсон.
"Розчленування тіла Тутанхамона, замовчуване офіційними джерелами, спонукає нас переглянути уявлення про археологічний тріумф і озирнутися на минуле більш критично", - зазначила вона.
Хоча методи Картера, що дали змогу розібрати одну з найзагадковіших фігур в історії, зазнали критики з боку одних дослідників, інші виступили на захист його розкопок.
Інші новини про Стародавній Єгипет
Історія давньоєгипетського міста Ахетатон, яке короткий час у XIV столітті до н. е. було столицею держави і домом бога-царя Ехнатона - це історія трагедії. Вважається, що на місто обрушилася чума, яка забрала життя дев'яти членів королівської сім'ї та багатьох сотень простолюдинів.
Однак новий аналіз фізичних і письмових джерел міста показав, що більша частина з них абсолютно неправильна. І спростував твердження про те, що місто впало через чуму.